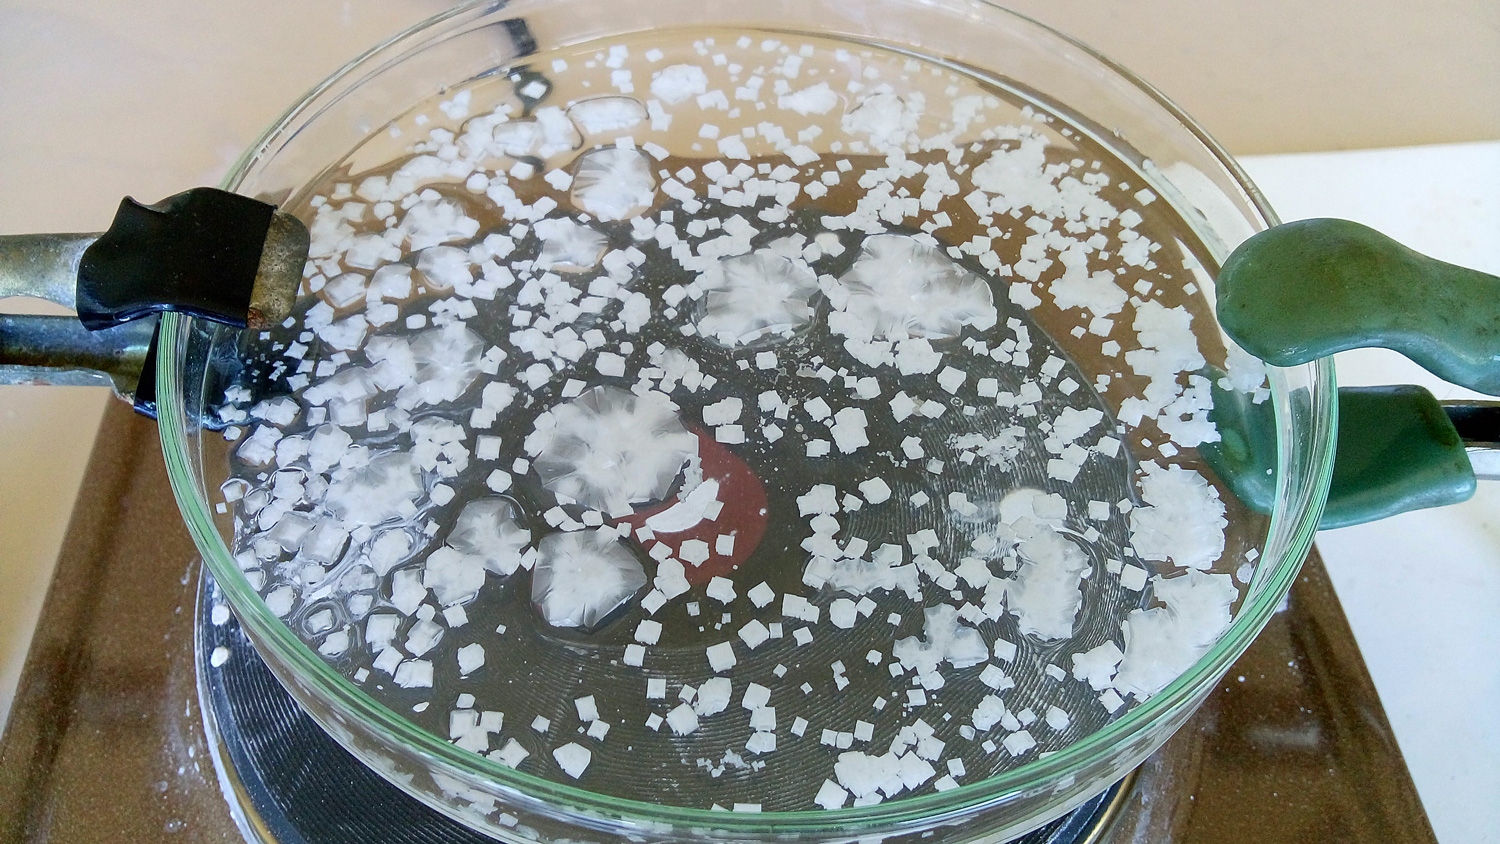

Tiempo de lectura: 4 minutos La cristalización es un método de separación que se parece bastante a la evaporación, pero este proceso del que vamos a profundizar en este artículo cuenta con la ventaja de ser más rápido. En Net Interlab somos especialistas en diferentes técnicas de separación de mezclas, por lo que con nosotros te informarás adecuadamente sobre todas ellas.. Métodos físicos de separación. 1. Filtración. La filtración es un método utilizado para separar sólidos de líquidos o gases. Se basa en la diferencia de tamaño de partícula entre el sólido y el líquido o gas. El sólido se coloca en un filtro, a través del cual se pasa el líquido o gas, dejando atrás el sólido. 2.

Sustancias puras y mezclas

Potente Enfoques para Metodo De Separacion Cristalizacion Que puede Comenzar a usar hoy mismo

Sustancias puras y mezclas

Generalidades de la cristalización •

ᐅ ¿Cómo funciona la cristalización? ⚡️ » Cómo Funciona

17 Ejemplos de Cristalización en química y vida cotidiana

El método de cristalización en la separación de mezclas

El método de cristalización en la separación de mezclas

FQ P3 Métodos de separación de mezclas evaporación y cristalización YouTube
![💥 ¿Qué es la Cristalización 💥 [Fácil y Rápido] QUÍMICA YouTube 💥 ¿Qué es la Cristalización 💥 [Fácil y Rápido] QUÍMICA YouTube](https://i.ytimg.com/vi/DMf8DbP3so8/maxresdefault.jpg)
💥 ¿Qué es la Cristalización 💥 [Fácil y Rápido] QUÍMICA YouTube

Cristalización YouTube

Introducción a la cristalización • Técnicas de laboratorio •

Cristalización » Qué es, características, formación, tipos, ejemplos

Los hechos Acerca de Cristalizacion Metodo De Separacion La fisica y quimica
Química 2 Métodos de separación

Lo que usted Puede hacer Acerca de Cristalizacion Metodo De Separacion en solo 10 minutos La

What are crystallisation? Definition, Types and Importance chemistry AESL

Cristalización Definición, proceso, uso y ejemplos de cristalización

CRISTALIZACIÓN E IMANTACIÓN Métodos de Separación de Sustancias Ciencia Sexto YouTube

Metodos de separacion de mezclas
El método de cristalización es una técnica de separación de mezclas que consiste en la formación y recuperación de cristales sólidos de una sustancia a partir de una solución líquida. La cristalización se utiliza comúnmente en la industria química para purificar y separar productos químicos, como sales, ácidos y bases.. Explicación teórica del método de separación por cristalización, en el que podemos separar de una mezcla homogénea, la sustancia sólida de la líquida, por ev.